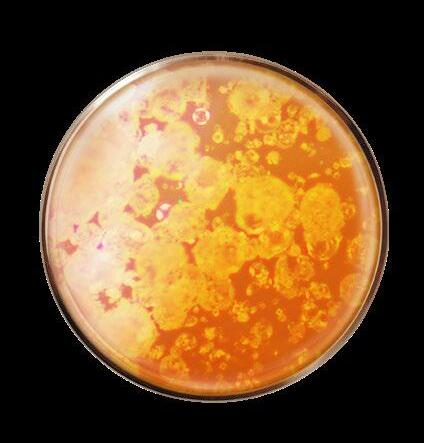

Wij zijn al 25 jaar toonaangevend op het gebied van nachtelijke huidveroudering en hebben nu een nieuwe generatie hoogwaardige verzorgingsproducten ontwikkeld die de huid ‘s nachts nog doeltreffender regenereren.
Nieuwe wetenschap: voor deze nieuwe formule hebben de laboratoria Dr. Pierre Ricaud de rol van melatonine in de huid en de invloed ervan op de nachtelijke celregeneratie onderzocht. Melatonine staat bekend om zijn bijdrage aan een goede nachtrust, maar veel minder om zijn werking op de huid. Melatonine wordt van nature ‘s nachts in de huid aangemaakt om de overdag opgelopen schade te herstellen. Het heeft een algemeen antioxiderende en ontgiftende werking op de huidstructuren. Naarmate we ouder worden neemt de productie van melatonine in de huid af. Dankzij een dubbel gepatenteerde technologie, de microRNA’s van biologische lavandula angustifolia, wordt de productie van melatonine gestimuleerd voor een geregenereerde, gladdere en stralendere huid bij het ontwaken.
Onze wetenschap:
dermocosmetische werkstoffen combineren met de kracht van geneeskrachtige planten*
Probiotica
zijn echte celherstellers, die het zelfherstelproces van de cellen ‘s nachts stimuleren.(1) 1 2
BEWEZEN DOELTREFFENDHEID
GEBOOSTE MELATONINE, GEREGENEREERDE HUID
VOOR NA
Geneeskrachtige plant*, microRNA’s van biologische lavendel verhogen de productie van melatonine in de huid, corrigeren rimpels en verlevendigen de uitstraling van de teint.(1)

De waargenomen doeltreffende werking zorgt voor een weldadig gevoel. Uit metingen met neurowetenschappelijke technieken blijkt dat het aanbrengen van de nachtcrème de perceptie van vermoeidheid vermindert.

Geëxplanteerde huidmodellen
Dermocosmetische werkstoffen
Bekend in de cosmetische en dermocosmetische wereld om hun intens doeltreffende werking.
Geneeskrachtige planten*
Bekend om hun weldadige werking op het hele lichaam. Wij kiezen fracties met specifieke eigenschappen voor de huid.
Al onze producten worden geformuleerd door onze laboratoria in Ile-de-France, vervaardigd in onze fabrieken in Bretagne en verkocht zonder tussenpersonen. (2)
Anti-rimpel Glow
Anti-vermoeidheid
+46% melatonine in de huid, antioxidant(2)
-33% oxidatieve stress, oorzaak van versnelde huidveroudering(2)
Hoogwaardige regenererende nachtcrème
probiotica + microRNA van biologische lavendel
Probiotica
Herstellende werking +
Geneeskrachtige plant* microRNA van biologische lavendel Stimuleert de aanmaak van melatonine in de huid

NIEUW
Hoogwaardig regenererend activerend nachtserum
probiotica + microRNA van biologische lavendel
Dit nachtserum wordt snel opgenomen om de huid te regenereren en glad te strijken. De activerende werking (gepatenteerde technologie), verdubbelt de opname van de werkstoffen(3) van de nachtcrème.
Elke avond aanbrengen onder de nachtcrème voor een versterkte regenererende werking.
Pompflacon 30 ml (183,33°) - Ref. 14020
55€
Onze iconische nachtcrème met probiotica is verrijkt met een dubbel gepatenteerde werkstof, microRNA van biologische lavendel, die de melatonine in de huid stimuleert voor een optimale regeneratie. Bij het ontwaken zijn rimpels gladgestreken en is de huid uitgerust en stralend. Geschikt voor alle huidtypen.



Pot 40 ml (112,5°) - Ref. 13836
45€
NIEUW
Hoogwaardige regenererende nachtcrème oogcontour
probiotica + microRNA van biologische lavendel

De doelgerichte regenererende nachtverzorging die rimpels gladstrijkt en de oogopslag ontspant. Bij het ontwaken zijn donkere kringen en wallen verminderd, de blik is weer stralend en fris en ziet er jonger uit. Zonder parfum.
Tube met canule 15 ml (173,33°) - Ref. 14168
26€
NIEUW *Cosmetische werkstof afkomstig van een geneeskrachtige plant. ● Frankrijk: gepatenteerd, Europese Unie, Verenigde Staten, Japan, China: patent ingediend (1) Klinische test bij 22 vrijwilligers na 10 dagen. (2) Resultaten met de crème. Ex vivo test, tweemaal daags gebruik gedurende 48 uur. (3) In vitro tests. °Tariefprijs in € per100 ml.
89% van de vrouwen constateert
- minder poriën
- minder imperfecties
- minder talg (1)
-12% rimpels (2)
Glycolzuur anti-onzuiverheden +
NIEUW Express gladstrijkend anti-rimpel masker


Puur hyaluronzuur & glycolzuur + biologische galanga
Heeft een onmiddellijk gladstrijkende werking en vult de huid op. 2 keer per week aanbrengen op een schone en droge huid. Geschikt voor alle huidtypen.
Pot 50 ml (70°) - Ref. 13066

35€
Gemengde tot vette huid met neiging tot imperfecties: kies voor de vloeiende crème met een matterende textuur die inwerkt op rimpels, imperfecties, zichtbare poriën en overtollig talg.


Normale tot droge huid: kies voor de opvullende crème met een romige textuur die zelfs diepe rimpels aanpakt en de huid comfort biedt.
NIEUW
Vloeiende crème tegen rimpels en onzuiverheden
Puur hyaluronzuur & glycolzuur + biologische galanga

Deze vloeiende en matterende crème vermindert rimpels en onzuiverheden zichtbaar na 7 dagen(2). Ze voorkomt ook nieuwe onzuiverheden na 28 dagen. Dagelijks ‘s morgens en ‘s avonds aanbrengen op het gezicht en de hals. Gemengde tot vette huid.
Pompflacon 50 ml (99,80°) - Ref. 13337


49€90
Een intensieve kuur met 4 hyaluronzuren met een onmiddellijk en geleidelijk effect op alle soorten rimpels en lijntjes.
4 tubes x 10 ml (162,50°) - Ref. 11149
x 2
Verdubbel het hyaluronzuur van uw huid(1) -31%
rimpels (2)
Opvullende anti-rimpel crème
Puur hyaluronzuur + flavonoïden van biologische galanga
Puur hyaluronzuur Gladstrijkend +
Geneeskrachtige plant*, flavonoïden van biologische galanga Opvullende werking
91% van de vrouwen constateert een minder getekende oogcontour(3)
Opvullende anti-rimpel oogverzorging

Puur hyaluronzuur + flavonoïden van biologische galanga
Deze lichte oogverzorging zonder parfum vult rimpels op en strijkt kraaienpootjes in 7 dagen glad(4) voor een ‘open’ oogopslag. Dagelijks gebruiken.
Tube met canule 15 ml (173,33°) - Ref. 10484

26€
Deze expert crème tegen rimpels is zowel effectief als aangenaam in gebruik: de formule met romige textuur vult diepe rimpels op en strijkt lijntjes glad. Dagelijks alleen of na het serum gebruiken.
Pot 40 ml (124,75°) – Ref. 10636
49€90
Dubbele opname van de werkstoffen bij gebruik van het serum voor de crème(5)
Activerend anti-rimpel serum



Puur hyaluronzuur + flavonoïden van biologische galanga

Wordt snel door de huid opgenomen om rimpels en lijntjes te corrigeren. Verdubbelt de opname van de werkstoffen(5) van de crème. Aanbrengen onder de crème voor een intens anti-rimpel effect.
Pompflacon 30 ml (216,67°) - Ref. 10828
65€
Liftend masker met niacinamide, pure fractie van lijnzaad, en dille


De ongelofelijke stretch textuur biedt onmiddellijk een huidaanspannend effect: in 15 minuten is de huid zichtbaar steviger en soepeler. De gelaatstrekken lijken wel gelift(2) !
Pot 50 ml (70°) - Ref. 11182
35€
+49% elasticiteit(1)
Niacinamide gladstrijkend +

Geneeskrachige plant* Pure fractie van lijnzaad, verstevigend
86% van de vrouwen constateert een liftend effect(3)
met niacinamide, pure fractie van lijnzaad, en dille
Deze parfumvrije liftende verzorging heeft een huidaanspannend effect en stimuleert de aanmaak van collageen en elastine voor een stevigere huid. Dagelijks aanbrengen.
Tube met canule 15 ml (173,33°) - Ref. 27289

26€
Liftende crème met niacinamide, pure fractie van lijnzaad, en dille Deze liftende crème vormt een ondersteunend netwerk op de huid en maakt haar zichtbaar steviger, voller en elastischer.

Pot 40 ml (124,75°) - Ref. 26710
49€90
+131% opname van de werkstoffen bij gebruik van het serum onder de crème(4)



met niacinamide, pure fractie van lijnzaad, en dille Dit serum boost de aanmaak van collageen en elastine voor een zichtbaar stevigere en veerkrachtigere huid.
Aanbrengen onder de dagcrème voor een verdubbelde opname van de werkstoffen(4)
Pompflacon 30 ml (216,67°) - Ref. 27011
65€
 *Cosmetische werkstof afkomstig van een geneeskrachtige plant. (1) Klinische test bij 28 vrijwilligers bij een tweemaal daags gebruik gedurende 4 weken. (2) % tevredenheid. Gebruikerstest bij 22 vrouwen, 15 min na gebruik. (3) Gebruikerstest bij 28 vrouwen bij een tweemaal daags gebruik gedurende 4 weken. (4) In vitro test op huidexplantaat 24 uur na gebruik.
*Cosmetische werkstof afkomstig van een geneeskrachtige plant. (1) Klinische test bij 28 vrijwilligers bij een tweemaal daags gebruik gedurende 4 weken. (2) % tevredenheid. Gebruikerstest bij 22 vrouwen, 15 min na gebruik. (3) Gebruikerstest bij 28 vrouwen bij een tweemaal daags gebruik gedurende 4 weken. (4) In vitro test op huidexplantaat 24 uur na gebruik.
93% van de vrouwen vindt dat de huid meer straalt(1)
NIEUW
Glowcrème stralende, gladde teint zonder vlekjes
Vitamine C + glabridine van zoethout Deze zachte crème werkt in op 3 belangrijke factoren om de huid een ideale glow˙ te geven en heeft een uitstraling boostende, gladstrijkende en anti-vlekken werking. De huid is glad, egaal en weerkaatst het licht perfect. Tekenen van veroudering zijn vervaagd. Dagelijks gebruiken. Geschikt voor alle huidtypen.



Pot 40 ml (124,75°) - Ref. 15322
49€90
NIEUW
Gestabiliseerde Vitamine C anti-vale teint
Geneeskrachtige plant*, glabridine van zoethout anti-vlekken

100% van de vrouwen constateert een stralendere teint(2)
Glowmasker
met vitamine C en biologisch citroenwater
De heerlijk frisse textuur vol ‘microwaterkussentjes’ strijkt de huid glad en zorgt voor een gezonde uitstraling in slechts 15 minuten(3)! 1 tot 2 keer per week gebruiken.
Pot 50 ml (70°) - Ref. 28291
35€
Glow-oogcontourverzorging stralend, glad, egaal
Vitamine C + glabridine van zoethout
De licht getinte formule verfrist de blik. Kringen zijn minder zichtbaar en de oogcontour is helderder. Dagelijks gebruiken. Zonder parfum.
Tube met canule 15 ml (173,33°) - Ref. 15572

26€
Pure vitamine C
10%
Serumkuur
met vitamine C 10%
Alleen of onder een crème gebruiken voor een ware boost wanneer vermoeidheid haar sporen achterlaat op het gezicht. Na 3 weken is de huiddichtheid verbeterd. De huid is gladder en egaler. Sporen van vermoeidheid zijn verleden tijd.

Pompflacon 30 g (216,67°) - Ref. 14260
65€

92% van de vrouwen constateert een anti-vlekken effect(1)
Lifting crème hals & decolleté


Vitamine B3 + biopolymeer van zoete amandel
Deze liftende crème voor de hals en het decolleté heeft een huidaanspannend effect en vermindert zichtbaar vlekken. De parelmoerachtige textuur laat een mooie, gesatineerde finish achter op de huid. Pot 50 ml (48°) - Ref. 97238

24€
Vitamine B3 5% Egaliserend + Geneeskrachtige plant*, biopolymeer van zoete amandel Gladstrijkende werking
EXTRA BEAUTYGEBAAR
Lipverzorging
met vitamine E, karité en olijfolie

Deze romige en subtiel geparfumeerde lippenbalsem verzacht en kalmeert de lippen dagelijks en houdt ze zacht en soepel. Ideaal om uw lippen in elk seizoen optimale bescherming te bieden.
Stick 4,8 g (145,83°) - Ref. 13783 7€
84% van de vrouwen constateert een zichtbaar gladdere oogcontour(2)
Gladstrijkende oogverzorging met biopolymeer van zoete amandel en escine
Ontkreukt en hydrateert de oogcontour, voor een uitgeruste en natuurlijk stralende oogopslag.
Tube met canule 15 ml (126,67°) - Ref. 23513

19€
95% van de vrouwen constateert een gehydrateerde, soepele en vitale huid(3)
Gladstrijkende fluid met biopolymeer van zoete amandel en vitamine E

Ontkreukt en hydrateert de huid in een handomdraai. De sporen van de nacht worden vervaagd en de huid is de hele dag fris en stralend.
Pompflacon 30 ml (96,67°) - Ref. 23815

29€
 *Cosmetische werkstof afkomstig van een geneeskrachtige plant. (1) Gebruikerstest uitgevoerd bij 28 vrijwilligers, bij een dagelijks gebruik gedurende 4 weken. (2) Gebruikerstest uitgevoerd bij 19 vrouwen na 28 dagen, bij een tweemaal daags gebruik.(3) Gebruikerstest bij 22 vrouwen onmiddelijk na gebruik.
*Cosmetische werkstof afkomstig van een geneeskrachtige plant. (1) Gebruikerstest uitgevoerd bij 28 vrijwilligers, bij een dagelijks gebruik gedurende 4 weken. (2) Gebruikerstest uitgevoerd bij 19 vrouwen na 28 dagen, bij een tweemaal daags gebruik.(3) Gebruikerstest bij 22 vrouwen onmiddelijk na gebruik.
10 JEUGDIGHEIDSFACTOREN NACHT & DAG
ANTI-RIMPELS GLADSTRIJKEND
ELASTICITEIT UITSTRALING
HUIDTEXTUUR REVITALISATIE
COMFORT SOEPELHEID VOEDING/ HYDRATATIE REGENERATIE/ ANTIOXIDATIE*
NIEUW
Sublieme nachtcrème

Rosa centifolia
Nacht na nacht stimuleert deze crème de 10 jeugdigheidsfactoren van de huid en biedt ze het comfort dat de huid gedurende de nacht nodig heeft. De romige textuur laat zich heerlijk inmasseren, heeft een omhullende en kalmerende werking en verfraait de huid.

Pot 40 ml (222,5°) - Ref. 32045


89€
Rosa centifolia
Capsule 40 ml (172,50°) - Ref. 32360

69€
Peptide antioxidant +
Geneeskrachtige plant**, microRNA van Rosa centifolia regenererende werking

NIEUW
Sublieme dagcrème
Rosa centifolia
Sublimeert de huid door haar 10 jeugdigheidsfactoren te activeren. De huid wordt gladgestreken, verfraaid en krijgt weer een fluweelzachte en frisse roze teint. De heerlijke textuur versmelt met de huid en hult haar in een cocon van zachtheid en comfort.
Pot 40 ml (197,50°) - Ref. 31460
79€
Rosa centifolia
Capsule 40 ml (147,50°) - Ref. 31757
59€
NIEUW
Rosa centifolia
Deze complete anti-ageing balsem is speciaal ontwikkeld voor de oogcontour en werkt in op de 10 jeugdigheidfactoren van de huid. De oogcontour oogt zichtbaar jonger.
Pot 15 ml (393,33°) - Ref. 99319
59€
100% van de vrouwen constateert een gevoede en herstelde huid(1)
Omega 3, 6 & 9 Anti-uitdrogende werking +
Karitéboter Voedende werking
Voedende en
Omega 3,6, 9 + karitéboter
Deze intens voedende verzorging biedt de zeer droge huid 48 uur comfort. De romige textuur herstelt en verzacht de huid.
Pot 170 ml (11,71°) - Ref. 21401



19€90
NIEUW 3-in-1 bodymilk





Puur hyaluronzuur + madecassoside uit centella

De drievoudige werking corrigeert effectief tekenen van veroudering op het lichaam: hydrateert 24 uur(2), strijkt glad en gaat huidverslapping tegen.
Pompflacon 195 ml (11,28°) - Ref. 17475
22€
 (1) % tevredenheid. Gebruikerstest bij 25 vrouwen, direct na gebruik. (2) Klinische test bij 19 vrijwilligers direct na gebruik. (3) % tevredenheid. Gebruikerstest bij 26 vrouwen, direct na gebruik. °Tariefprijs in € per 100 ml. *In vitro test.
(1) % tevredenheid. Gebruikerstest bij 25 vrouwen, direct na gebruik. (2) Klinische test bij 19 vrijwilligers direct na gebruik. (3) % tevredenheid. Gebruikerstest bij 26 vrouwen, direct na gebruik. °Tariefprijs in € per 100 ml. *In vitro test.
De huid biedt ons bescherming tegen externe invloeden van buitenaf die de huidbarrière verzwakken. Het is van daarom essentieel om de hydrolipidenlaag, waaruit deze barrière is opgebouwd, langdurig te beschermen en te versterken. Kies daarom voor verzorgingsproducten verrijkt met omega 3, 6, 9 met omhullende texturen. De huid wordt beter beschermd, is stralender, soepeler en voelt weer comfortabel aan.




Glycerine + microkorreltjes kokosnoot
Een scrub die bij contact met water verandert in een melk om de huid zacht te exfoliëren.
Tube 150 ml (10,60°) - Ref. 20886

15€90
Omega 3, 6 & 9
Anti-uitdrogende werking +
Extract van ahornschors Beschermend
96% van de vrouwen constateert een gevoede en comfortabele huid(3)
met vitamine E en biologisch haverextract



Een weldadige douchecrème, die het trekkerige gevoel van de huid verzacht en verlicht, voor een moment van verzorging en plezier onder de douche.
Tube 200 ml (6°) - Ref. 11708
12€


met extract van ahornschors en omega 3, 6 & 9
Om de huid intensief te voeden tijdens perioden van extreme kou en haar te beschermen zodat ze comfortabel en soepel blijft. Een heerlijke honinggeur en een ultracocooning textuur. Dagelijks gebruiken. Voor alle huidtypen. Pot 40 ml (97,50°) - Ref. 24364
39€

Hyaluronzuur Gladstrijkend
NIEUW
Terre de soleil bronzingpoeder

Een luchtige poedertextuur die zich makkelijk laat aanbrengen voor een zonnige teint in een handomdraai.
Doosje 10,5 g 30€

Teintserum met hyaluronzuur

Een serumtextuur die versmelt met de huid voor een perfecte, gladde en egale teint, 12 uur lang.
Pompflacon 30 ml

36€
Liftende foundation
Met niacinamide en biopolymeer van zoete amandel


Een comfortabele crèmetextuur die de huid lift en de teint egaal maakt. Hoge dekking en comfort de hele dag lang.
Pot 40 ml
40€
Gladstrijkende basis met hyaluronzuur
Een romige textuur verrijkt met hyaluronzuur voor een gladde, matte en egale teint. Ideaal als make-up basis. Zonder parfum, perfect voor het gezicht en de oogleden.

Pot 15 ml (173,33°) - Ref. 92954
26€
Volumegevend borsteltje
Omhullend borsteltje
Tint 1
Ref. 96999
Tint 2
Ref. 97074
Tint 3
Ref. 97194
Tint 4
Ref. 97267

met hyaluronzuur en escine van paardenkastanje
Een corrigerende concealer voor een uitgeruste, gladde en heldere oogoplslag.
Tube met canule 10 ml


24€
Mascara volume met vitamine B3-B8 en provitamine B5




Flacon 7,8 ml
23€
Intens Zwart Ref. 16101
Diep Bruin Ref. 16453
Mascara lengte & krul met vitamine B3-B8 en Arabische gom
Flacon 7,8 ml
23€
Intens Zwart Ref. 16776
NIEUW Wenkbrauwpotlood
Potlood 1 g
9€
Diep Bruin Ref. 17068
Lichtbruin Ref. 18744
Donkerbruin Ref. 94475
Pruim Ref. 18575
Potlood 1,1 g
12€
Blauw Ref. 18406
Blauw Ref. 18222
Zwart Ref. 18076
Potlood 1,4 g
22€
Geïriseerd Taupe Ref. 68438
Geïriseerd Beige Ref. 67443
Geïriseerd Zwarte Kers Ref. 92435
Geïriseerd Groen Ref. 69016

Tarweproteïne herstructurerend



NIEUW
Versterkende antihaarbreuk shampoo



Beschadigd haarnatuurlijk of gekleurd
1,8 X minder haarbreuk na het 1e gebruik.(2) Schuimende crème textuur.
Flacon 250 ml (4,8°) - Ref. 11305 12€
- BREUK + VOLUME + VOEDING
ZONDER SULFATEN(1) & ZONDER SILICONEN + 91% NATUURLIJKE INGREDIËNTEN
NIEUW Versterkende volumeshampoo

Fijn haar - natuurlijk of gekleurd
+ volume: voor 88% van de vrouwen.(3) Schuimende gel textuur.
Flacon 250 ml (4,8°) - Ref. 11586 12€



Guargom volumegevend
NIEUW Herstellend en verzorgend masker
Droog haar - natuurlijk of gekleurd
Gevoed en hersteld haar: voor 96% van de vrouwen.(4) Rijke crème textuur, gemakkelijk aan te brengen.

Tube 125 ml (12,8°) - Ref. 95742 16€

Jojoba olie voedend



+
Panthenol versterkend
Geneeskrachtige plant*



NIEUW Versterkende herstellende en voedende shampoo
voedende shampoo Droog
haar - natuurlijk of gekleurd
+38% voeding na het 1e gebruik.(5) Schuimende crème textuur.
Flacon 250 ml (4,8°) - Ref. 11427 12€
+ HANDIG
NIEUW Herbruikbaar pompje om op uw flacon te schroeven Ref. 97445 1€90
*Cosmetische werkstof afkomstig van een geneeskrachtige plant. Behalve jojoba olie. (1) Zonder sulfaat oppervlakte-actieve stoffen. (2) 1,8x minder haarbreuk na het 1e gebruik vs een klassieke shampoo – gebruikerstest uitgevoerd gedurende 3 weken. (3) % tevredenheid. Gebruikerstest bij 26 vrijwilligers direct na gebruik. (4) % tevredenheid. Gebruikerstest bij 26 vrijwilligers gedurende 4 weken. (5) Doeltreffendheid getest bij een ex vivo toepassing op een haarlok. °Tariefprijs in € per100 ml.
Lavendelblauw 98181
Ivoor 98346
Kaki 98430
LICHAAMSVERZORGINGEN
Rosé Goud 98595
Paars 98267
Taupe 98514
MAKE-UP VOOR DE LIPPEN
• Vloeibare balsem voor vollere lippen met hyaluronzuur en macadamia-olie - Flacon 8 ml 24
Zwarte Bes 97718 Snoepjesroze 97468
Zuurtjeskoraal 97554 Grenadine Rood 97869 Geglaceerd 97349
MAKE-UP VOOR DE NAGELS
• Versterkende nagellak - Flacon 5 m 10
Koraalrood 92319 Roze Naturel 91731
Paars 91887 Donkere Kers 92270
Rood Klaproos 91951 Bordeaux 92193
Roze Tulp 91835 Rood Hoogrood 92021 Beige Paarlemoer 91388
• Voedende olie 2-in-1 nagels & nagelriemen met jojobaolie en zoete amandel - Flacon
+
Prebiotica,stimuleren het respect van het microbioom

Geneeskrachtige plant* hydrolaat van biologische roos kalmerende werking
NIEUW
Micellair reinigingswater
gezicht, ogen & lippen
Een verfrissend micellair water voor een doeltreffende én milde reiniging van gezicht, ogen en lippen. Ook geschikt voor de gevoelige huid. Parfumvrij.
Flacon 200 ml (6°) - Ref. 95021 12€

NIEUW
Micellaire reinigingsmelk

gezicht, ogen & lippen
De comfortabele melk die gezicht, ogen en lippen in één gebaar reinigt, voor een schone, zachte en gekalmeerde huid, zelfs de gevoelige huid. Parfumvrij.

Pompflacon 195 ml (6,15°) - Ref. 95194 12€
NIEUW
Micellaire reinigingscrème gezicht
2 SCRUB & VERHELDER 1 tot 2 keer per week
NIEUW
Gezichtsscrub met microkorrels gezicht
De frisheid van een reiniging met water en de zachtheid van een crème in een reiniging met een subtiele rozengeur die zelfs de gevoelige huid reinigt zonder haar uit te drogen.


Tube 120 ml (10°) - Ref. 95339 12€
Verrijkt met zachte klei en poeder van abrikozenpitten, voor een stralende, zuivere huid. Onzuiverheden worden verwijderd, geëxfolieerd, voor een zuivere en heldere huid. Frisse rozengeur.
Tube 50 ml (24°) - Ref. 95288 12€

